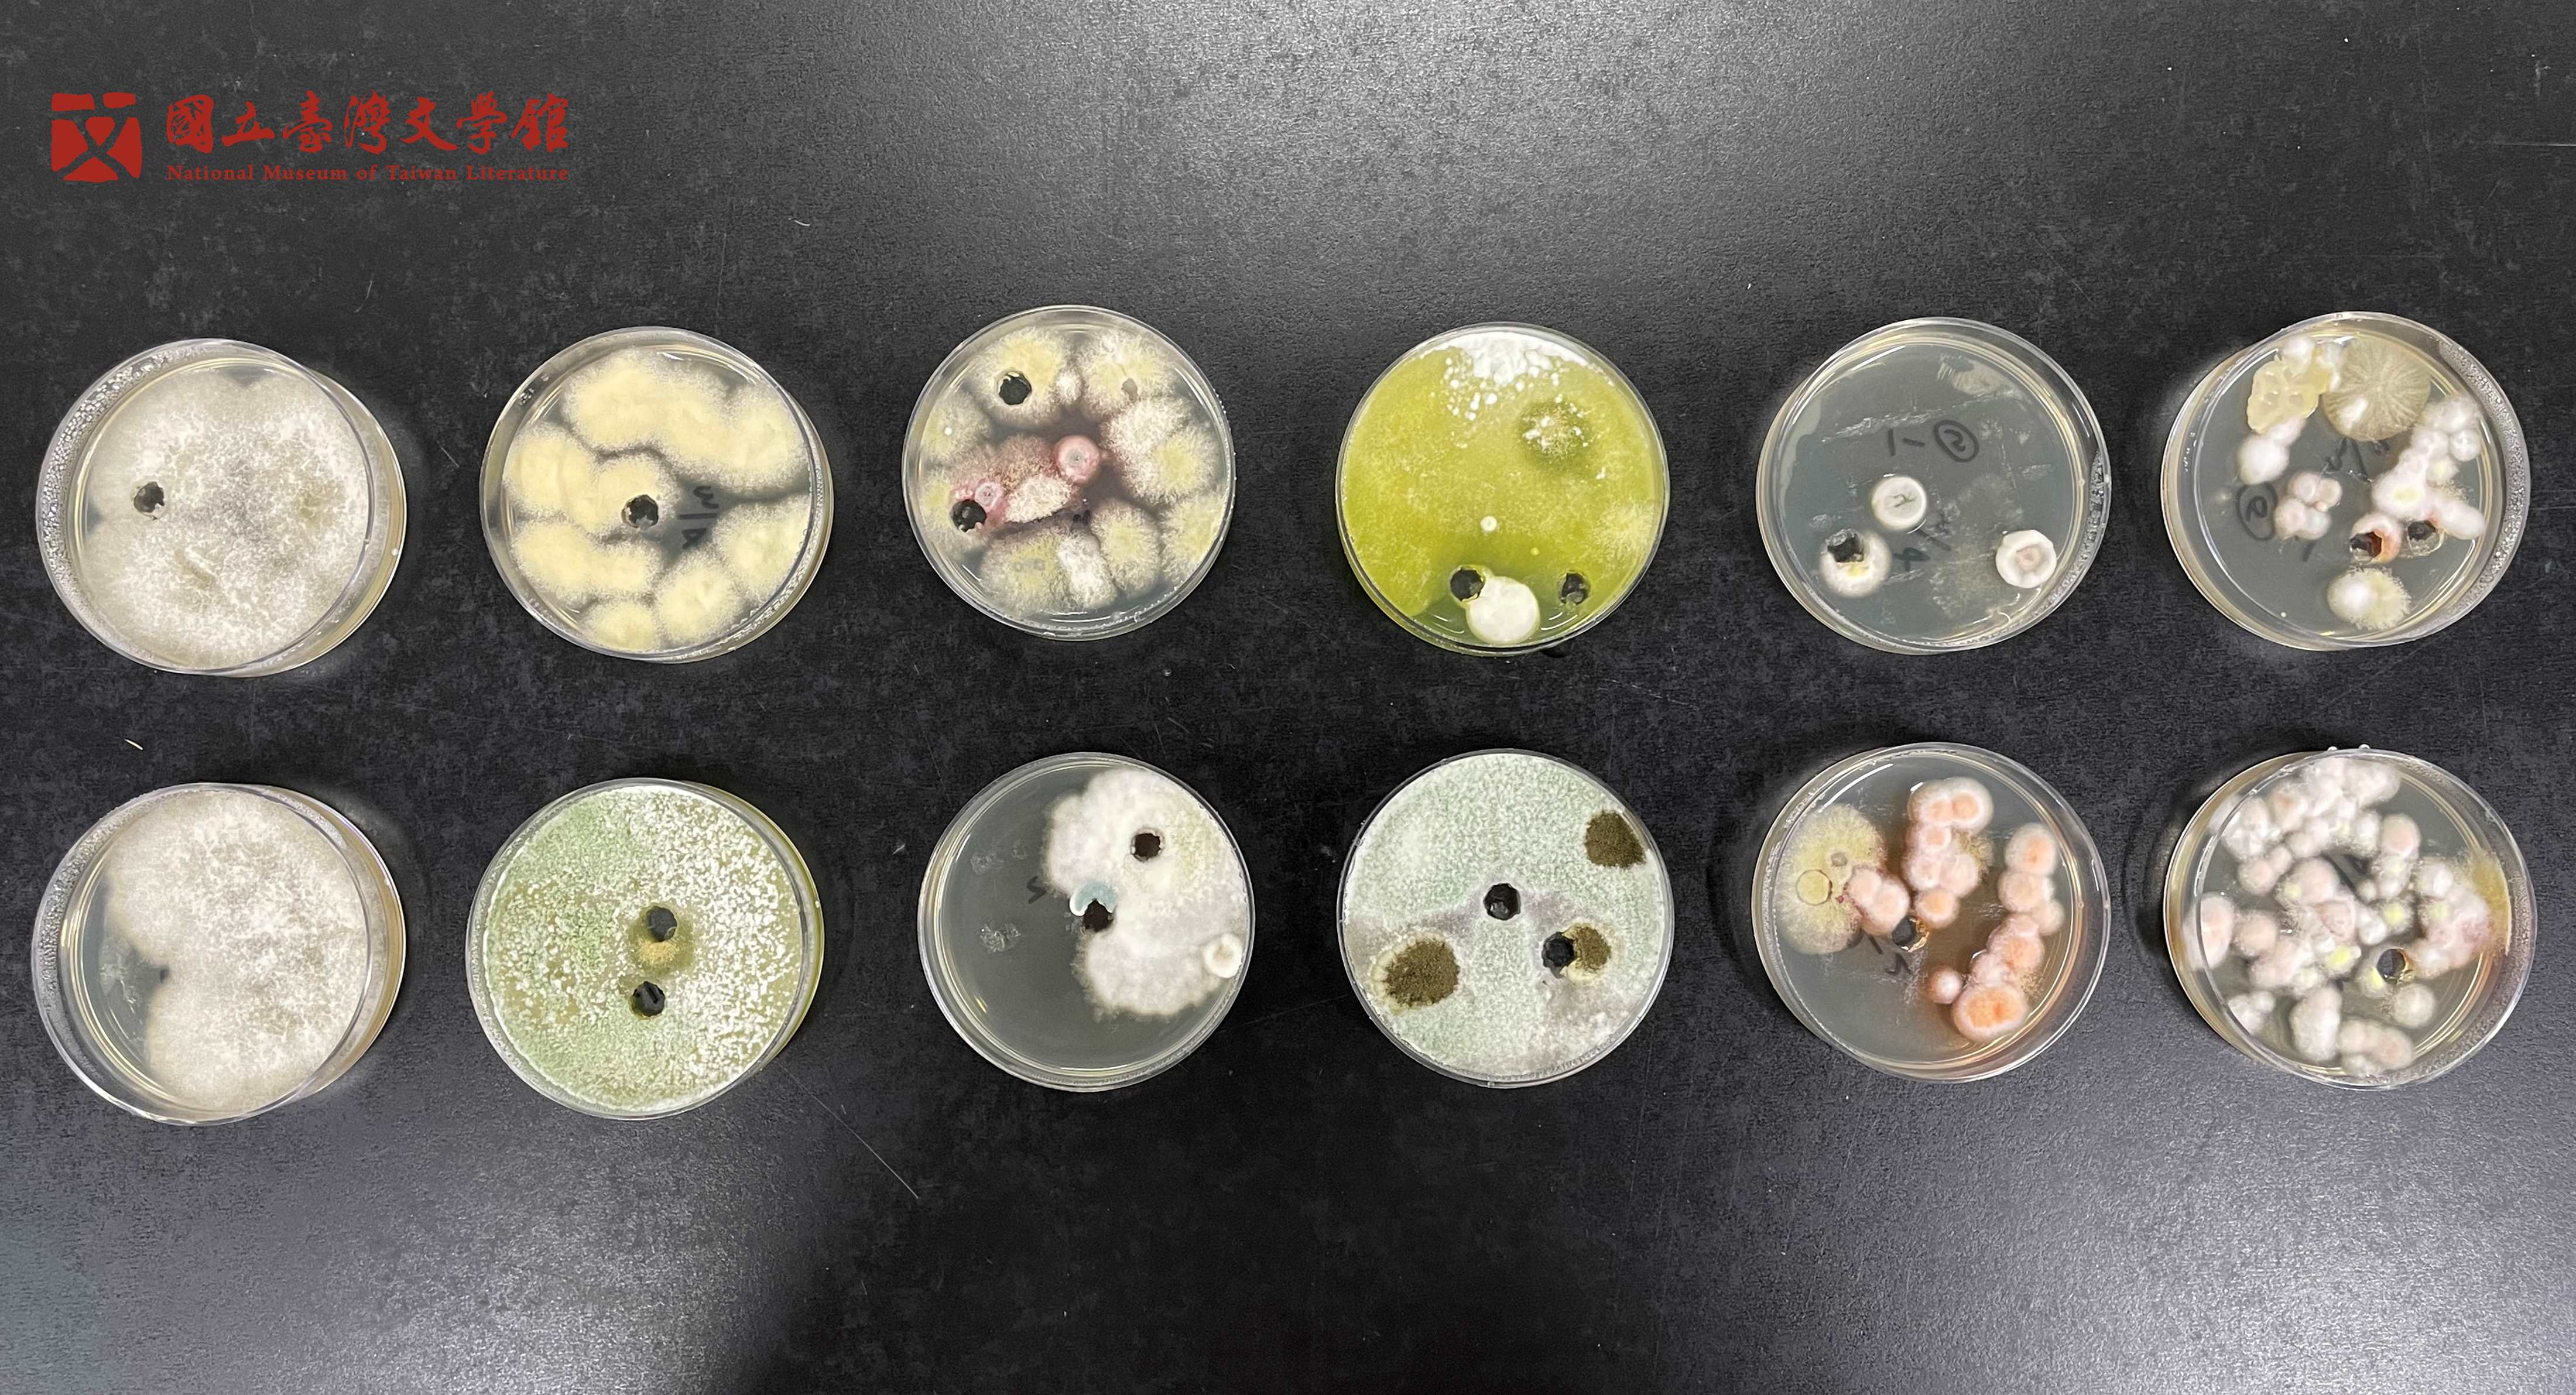
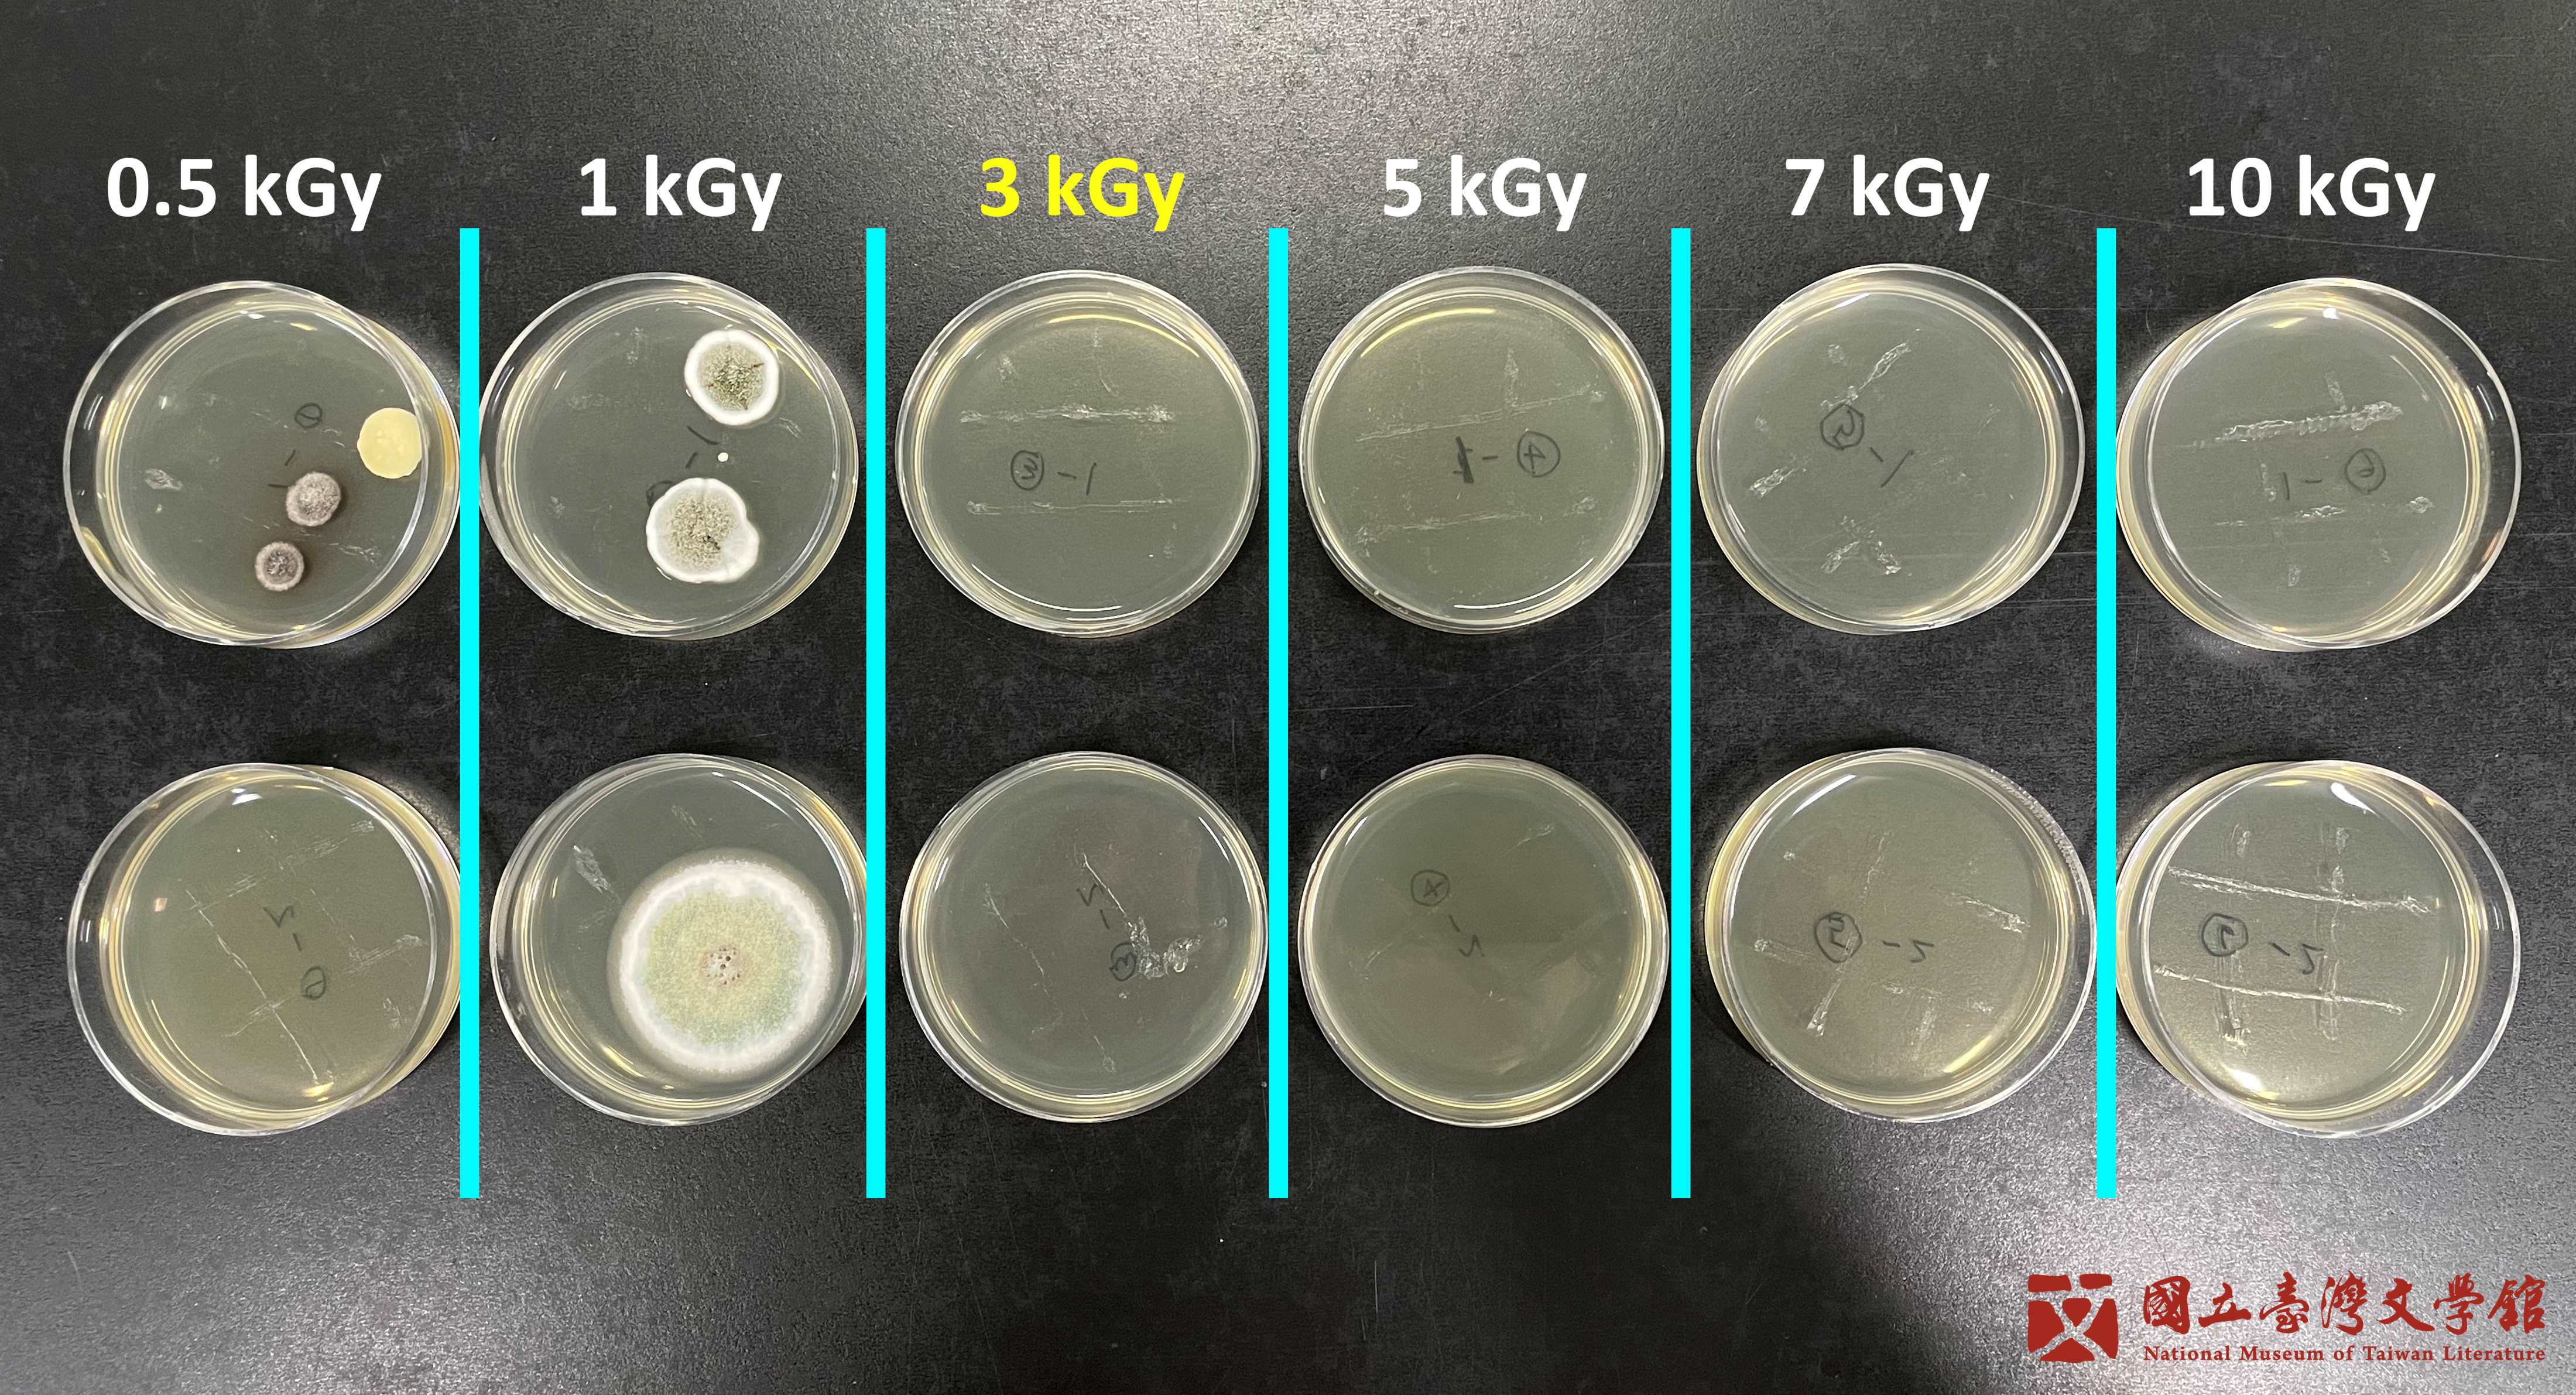

◍ 書寫史中不可承受之輕 ◍ 墨水筆的美麗與哀愁 ◍ 冬夜將盡——再現呂赫若的文學生命 ◍ 吉光片羽 自足珍矣
◍ 浴火手稿重生之路 ◍ 為著前進而前進 ◍ 攜手相伴修護紙瑕 ◍ 畫說文壇狂士

遠離了人聲喧囂的大廳,穿越文學光廊,彷彿走進時光隧道,探訪文物走過的一生光景。
在本館地下室靜謐的一隅,典藏人員為文物經過仔細地逐一登錄建檔,為其專業問診探查身世,得到一紙專屬的調養處方,目的是為了減緩光陰歲月在文物身上留下更多的痕跡。本館自2009年起打造文物修護室,歷經了14個年頭,替無數的珍貴文學文物提供各項完善且健全的醫療支援,多年下來累積了許多精彩案例。在物件本身既有的基礎之上,加上專業的悉心養護,才是這些文學史料更加源遠流長、歷久彌新的關鍵。
每一次的修護執行,背後皆是經過完整的史料考證與審慎評估。紙張破洞的填補,修護師須從選紙、染色、剃邊、搭接等依序細心地執行,甚至為了認識手稿、藏書的組成與結構,還需認識造紙、裝幀技術、材料科學等各種細緻環節。秉持著嚴謹的保存理念與實踐,臺文館不僅僅修復了物件本身,也完整守護了文物背後的綿延的歷史情感與記憶。

書寫史中不可承受之輕
從藏品故事談特殊基底紙材的修護
2001年,臺文館於籌備期間舉辦了「臺灣史料捐贈運動」,前副總統呂秀蓮為響應與支持,捐贈了獄中創作手稿。臺文館於2008年執行四張小說手稿「《這三個女人》部份草稿」修護計畫。

⭔ 呂秀蓮《這三個女人》部份草稿(左)、〈軍法大審最後陳述原稿〉(右)
兩件小說原稿,入館前以雙面膠浮貼於影印紙,再重貼於海報紙上展出(國立臺灣文學館典藏)
在「桃之夭夭,灼灼其華: 桃園作家訪談錄」一書中提及呂氏在獄中創作小說時將原稿書寫於衛生紙的動機:「衛生紙質地軟,又薄又皺,很不好寫,但為了不要被查禁,這是最好的就地取材」。為了避免創作被抽查收回,她以塑膠盆翻面墊底,衛生紙為稿紙,克難寫作並妥善收存,寫過的衛生紙揉成團後藏在棉被中送出監牢外,以衛生紙書寫的小說《這三個女人》後來才有機會發表、付梓,乃至於改編成電視劇。獄中完成的「這三個女人」與「情」兩部小說,皆寫作於衛生紙上。

⭔ 移除文物背後膠漬
以有機溶劑甲苯施於雙面膠,慢慢將衛生紙、背後襯紙與雙面膠分離。其餘殘留襯紙,以純水局部潤濕後,小心地揭除。(國立臺灣文學館典藏)
單薄的紙張,亙古以來承載了無可計數的知識寶藏,特別是衛生紙漿料成分複雜且質地軟又薄皺,經年累月下又因為黏膠造成的局部膠漬、破損及脆裂等多重傷害,實為保存的一大挑戰。修護時首重移除不穩定的因子,加強衛生紙結構,並透過妥善的典藏保存,讓珍貴手稿得以再次展示於大眾。

冬夜將盡——再現呂赫若的文學生命
西式裝幀日記的保存修護與形式還原考量
2020年7月盛夏,呂赫若次子呂芳雄先生帶著日記前來臺文館,小心翼翼地從袋中拿出父親僅存唯一傳世的手稿。歲月的氣息停駐書盒和滿佈膠帶的日記封面,翻開內頁隨著其中上乘載的筆觸,彷若能窺探曾經閃熾絢麗的文青理想,匆匆畫過一個烽火煙硝的時代。此件呂氏唯一歷劫殘存的手稿,於1942至1944年以日文書寫。在戰後漫長的白色恐怖期間,日記始終由呂氏長子審慎保存,直至1993年於田野調查過程始公諸於世。

⭔ 呂赫若日記(1942至1944年)
(國立臺灣文學館典藏)
修護主要從膠帶、書籍裝幀結構等問題著手,拆解書籍後,於牛皮紙內發現殘留的深藍黑色書皮布,推測為原始書背材料,因牛皮紙書背與影印字樣為後人補強結構所加,經與研究人員討論後決議讓日記回歸原始樣貌。修護師悉心逐一組回內頁後,重建書背與封面, ,讓家屬之間心心念念惦記著缺席的父親,唯一留下帶有溫度與厚度的重要物件,得以完整再現。期間也透過紀錄片的拍攝,仔細記錄了諸多修護細節也訪談相關研究者,從第一手珍貴史料讓讀者窺見一個時代的心靈。
⭔ 文物再現 守護永恆
呂赫若日記修復紀錄(國立臺灣文學館製作)
凡是觸及文學的地方,他毫不保留地傾瀉專注而虔誠的精神。呂赫若的作品傳達著半個世紀以前的歷史召喚,台灣知識分子的精神出路就在這塊土地,這座奮力在北半球泅泳的夢島。呂赫若有意無意牽引著讀者走向他的時代,投以深情的回眸。
—— 陳芳明:麻墟之花——吕林莉小說的藝術光澤
本書記錄了呂氏文學藝術活動最活躍的三年間之生活,交遊,具有極高的學術價值,可以補足呂赫若研究的空白地帶,拓展研究;即使是對於一般讀者而言,日記當中所載之各種紀錄,亦是認識該時代彌足珍貴的史料。

墨水筆的美麗與哀愁
劉吶鷗日記1927的修護:鞣酸鐵墨水與西式裝幀書籍的保存議題
近百年前的初代文青劉吶鷗,以洋派的墨水筆書寫日記,此類墨水筆在西方傳世悠久,亦是臺灣地區早期文人書寫時的首選,包括賴和、蔡培火、呂赫若等人。然而此墨水中的成分,卻會加速紙張水解與氧化,要完整保留珍貴的字跡,更需悉心的照料與呵護。
《新文藝日記1927》以墨水筆書寫於圓背形式的精裝筆記本,原始狀況欠佳,除了發黴、書皮分離,墨水筆因成分特殊,含有鐵離子與沒食子酸等成分,以至於隨著時間推移,字跡顏色從深藍黑轉變為深褐色,亦造成紙張氧化、脆化、斷裂,嚴重影響了閱讀與保存。
修護時以穩固書籍與內頁結構為首要考量,並移除原始黏貼破損書頁的膠帶,加固書頁,將書籍結構拆解後一步步重建,讓日記得以恢復過往風華。

⭔ 穩固書籍與內頁結構
原書頁為機器量產之縫法固定,修護後採手工裝幀——科普特式Coptic縫法將書頁縫回,並以圓背錘調整背脊形狀,以符合原有裝訂形式。(國立臺灣文學館典藏)

⭔ 劉吶鷗日記1927
《新文藝日記1927》修護後將書背襯布與書皮黏合,扉頁與書皮紙板黏合,還原完整的書籍結構。(國立臺灣文學館典藏)


吉光片羽、自足珍矣
拾綴遺落的詩篇:中式線裝書籍的修與護
施瓊芳、施士洁為清領時期臺灣的父子進士,臺灣所見施士洁詩文作品,最早是由黃典權依據施氏手稿所編輯的《後蘇龕合集》。施士洁文物於2017年捐贈入館,分別有《喆園吟草》四冊(缺一、二卷),《後蘇龕稿》四冊、《後蘇龕草》二冊。經比對內容,《喆園吟草》及《後蘇龕草》這六冊不見於已出版之《後蘇龕合集》及《全臺詩》。《後蘇龕稿》四冊版本亦與已出版之《後蘇龕合集》略異,彌足珍貴。
黃典權於《後蘇龕合集·弁言》稱施:「生平淡於仕宦而勤於吟詠,所歷、所見、所文,概入詩文,因而他替有關的時地保存了豐富的史料。」也因此批文物年代久遠,狀況不佳,後經修護師悉心地將蟲蛀嚴重的書頁逐頁悉心拼湊、整理、小托後,再依循原裝幀形式縫回,以還原文物完整的樣貌。

⭔ 施士洁《後蘇龕稿》
此批線裝書受嚴重的蟲蛀,書頁多沾黏無法分離,造成手稿字跡無法辨識,亦無從翻閱。部分書稿有受潮且黴害侵擾的問題,入館後隨即單本隔離,並分年度陸續完成修護處理。(國立臺灣文學館典藏)

文物知識小科普
東 西 裝 幀 , 有 點 像 又 不 太 像 ?
翻開裝幀的歷史,東方書籍結構的遞嬗,早從先秦的編策(簡牘)、片繒(帛書)、軸裝(手卷)、摺本(冊葉、經摺裝)到印刷裝幀成冊(蝴蝶裝、包背裝、線裝);與此相近的歷程,也顯現於西方世界的古籍演變,如西亞兩河流域的泥版、古埃及的紙莎草紙卷、古歐洲的羊皮紙卷,再到印刷後摺疊裝訂的紙本書冊型式。廣義來看,不論是東西方文化,書籍皆不約而同由平面演變到立體形貌,更在發展漸趨成熟時,邁入印刷裝訂型式。

⭔ 東西裝幀差異圖
《國立臺灣文學館館員論文集刊2020》,頁246。
19世紀後,因東西方文化交融,開始大量引進現代化印刷機械及創辦出版社,除了西式原有的精裝書本外,傳統東方裝幀方式也納入西法,採用西式材料融合中式包背裝、線裝等形式的平裝書因應而生。尤其在20世紀前、中葉的臺灣書影中,可見傳統裝幀過渡到現代時,東西方元素互相影響的軌跡,在西式材料、外觀內,藏著中式裝訂法、封面編排及內容翻閱方向,稱之為「鐵絲平釘」的裝幀書籍。而今各地出版的書籍,於裝訂機械幫助下,普遍趨於雷同,大多以線縫、上膠、活頁(環裝)、加上釘針等方式,製作現代各式精裝與平裝書本。

⭔ 鐵絲平釘裝釘範例
右側裝訂邊以訂書針裝訂。(國立臺灣文學館典藏)

浴火手稿重生之路
重建消逝的靈光──火吻後的手稿再現
2019年5月11日,一場太麻里的暗夜大火,燒毀原住民作家撒可努創辦的獵人學校,也波及手稿存放的自家。火災的發生,因為燃燒 、熱與煤煙沉澱的損害,加之灑水搶救後,不可避免危害文物所傳承的文化、記憶,產生難以評估與不可逆的結果。由於火災當下以搶救為先,一般情況下,災後針對殘存文物的處理多是被忽略的,依據災損程度,常伴隨複合的劣化狀況,極大化地增加修護與保存火損物件需面臨的挑戰。

⭔ 手稿到館開箱所見狀態
手稿紙張嚴重焦脆。(國立臺灣文學館典藏)
不幸中的大幸是,災損現場中倒下的木櫃,保護了作家跨度超過10年的一批珍貴手跡,於是同年6月,臺文館在撒可努許可下,帶回這批火損手稿,期待透過修護得以再現手稿蒙塵的靈光。入館搶救過程陸續經前期放射線除黴研究、紙力結構變化分析,煙味有害性檢測後,最終制定一系列修護策略與執行修護,並為其設計專屬典藏維護措施,使破碎的手稿得以再被安全的研究與展示應用。

⭔ 撒可努手稿
紙張歷經了大火、消防灌救與風乾,留下嚴重焦脆、黴害、媒材暈染、透色、漬痕、變形、黑炭覆蓋及不良物質殘留等複雜劣化問題,一定程度影響手稿紙力結構與外觀,相當不利保存。所幸殘存手稿仍留有約2/3的紙張,交由國立臺灣文學館接下修護的任務,期許蒙塵的手稿得以再現靈光。撒可努手稿修護後手稿存放於量身訂製的保護盒。(撒可努(Sakinu Yalonglong)提供)

文物知識小科普
使 用 輻 射 好 可 怕 ?
打開新聞,看見核災汙染總是讓人聞輻色變,但使用輻射真的是好可怕嗎?其實輻射如果用的巧,不僅是常見應用在食品、醫藥、工商業產品的消毒、除蟲中,還可以用來 處理文物上的黴害問題,就讓我們透過修護撒可努手稿的案例一探究竟吧!
⭔ 手稿除黴測試採樣
國立臺灣文學館典藏
本次修護是採用鈷60(Co-60)所產生γ輻射進行照射。其特點是照射不殘留輻射,並藉由照射時間長短,控制累積的輻射劑量,進而破壞黴菌細胞核(DNA),完成除菌作業。然而文保領域認為輻射應用,也可能造成紙張的物理化學性降解,所以本次修護研究中,透過測試0.5、1、3、5、7、10kGy的低劑量輻射照射受測物,找尋針對該批手稿最低與有效的除菌輻射劑量,減少對手稿紙張的傷害。
⭔ 輻射處理前的黴菌培養基
國立臺灣文學館典藏
⭔ 輻射處理後的黴菌培養基
可見經過3kGY劑量的照射後,黴菌已不再生長。實驗結果顯示透過妥善的修護處理,可讓受過輻射照射而下降的紙張強度再度恢復。(國立臺灣文學館典藏)
經黴菌採樣與輻射照射前後比較滅菌效果。結果顯示使用3kGy,即可作為此批手稿除黴的安全有效劑量,滅菌後歷經14天培養,皆無黴菌生長。經傅立葉轉換紅外光譜結果檢視紙張樣本,在3kGy劑量照射後,纖維圖譜並無明顯化學鍵結改變。紙張耐折度測試結果,也可透過修護方法回復纖維照射輻射後下降的物理結構力,由此讓輻射反而成為幫助修護撒可努手稿的秘密武器呢!
為著前進而前進
互相信賴與提攜,賴和手稿修護與擬真全紀錄
臺文館近年持續展開與各地文學館舍交流互動,組成文學館家族,也鑑於地方館舍受限人物力資源,普遍難以顧及典藏保存議題,因此透過建立文學主題館舍間的典藏保存合作機制,提供文物典藏修護專業協助,為原環境空間、資源與人力皆有限之中小型館舍,進行作家相關物件的修護任務,目標以臺文館大館帶小館,肩負保存臺灣文學的共同使命。
2021 年臺文館出版《新編賴和全集》重新整理賴和手稿文物資料,並著手與賴和文教基金會進行手稿文物徵集。原存放於賴和紀念館的手稿原件,有感於文物保存不易,近幾年陸續捐贈予臺文館。而考量該館需對外營運展覽,遂透過館舍合作計畫協助原件的修護、數位化、專業的擬真複製手法,讓原件得以妥善保存之餘,也能藉由擬真物件取而代之在賴和紀念館展出,持續傳遞作家精神與文字力量。

⭔ 賴和〈女性的一步前進〉
此批手稿為賴和長孫賴悅顏所捐贈,多以鋼筆書寫於稿紙上,嚴重者曾經撕裂、揉成團,造成多處嚴重摺痕,斷裂為幾個區塊,無法持拿,且字跡幾經磨損,已有部分無法辨識。其餘手稿亦有局部缺失、摺痕、媒材輕微鏽蝕等問題。(賴和紀念館提供)
⭔ 進擊的修護——賴和手稿擬真記
緣於臺文館2021年出版《新編賴和全集》,重新整理賴和手稿文物資料,並向賴和文教基金會進行文物徵集。透過手稿擬真展示品的製作與推廣計畫的執行,讓原件得以獲得妥善保存環境,擬真展示品亦能在紀念館舍中持續傳遞作家文物展示與傳承的精神。(國立臺灣文學館製作)

攜手相伴修護紙瑕
情意與記憶的延續,紫霞堂手稿藏書的保存修護之路
紫霞堂典藏臺灣漢學發展與臺文的許多珍貴史料,所藏文物逾千件,雖然該堂已傾力保存這些珍貴知識寶藏,但文物經百年輾轉流傳至今,仍不免出現劣化。透過合作計畫,藉由完整的2年期程,協助紫霞堂完成928件文物建檔編目、除蟲與保護措施製作,121件文物數位化,30件文物修護,在有限的時間內以手稿、攝影或較具珍稀性的孤本為優先。
受限於典藏環境與保存人力,能夠協助百年珍貴藏品狀況穩定,為現地保存提供強力的後援,從而延續地方性的文化脈絡,亦是文學家族精神的最大體現。

⭔ 整理書頁
紫霞堂部分文物受蟲蛀導致書頁沾黏也相當嚴重,花了很多時間才將書頁一一分開,整理拼湊。透過重新裝幀、攤平、小托等工序,逐一穩定文物的現況。(國立臺灣文學館典藏)

⭔ 鄭家珍《雪蕉山館詩稿》
鐵絲平釘的書籍裝幀方式鏽蝕嚴重,修護後也於相同位置以線裝取代釘針,進行重新裝幀(紫霞堂提供)

畫說文壇狂士
施明正手繪鉛筆素描——人物畫像修復
施明正於1967年在獄中寫了第一篇小說《大衣與淚》,從此展開了他文學生涯,同時亦有詩作、畫作、雕塑的發表,詩人、學者林瑞明在《施明正集》的序文中形容其為「以生命撞擊藝術的魔鬼」,認為他「在臺灣文學史上具有無人可取代的重要位置」。
臺文館典藏來自鍾理和紀念館提供的19件施明正創作的人物速寫,為1979年鍾理和紀念館成立開館之初,受許多作家、畫家的支持,包括施明正,亦完成了數十幅的作家速寫,框裱後供紀念館陳列。
簡而有力的筆觸細膩刻畫了幾位詩人、小說家的神韻。入館前因坊間框裱材料不佳,及典藏環境的因素,造成同一批作品保存狀況有極大的落差,嚴重者即便經過修護,黃化的減緩效果亦是有限。透過不當材料的移除,並經由妥善的處理,得以重新拼湊一幅文壇創作者的群像。

⭔ 清洗黃化嚴重的畫作
以色差檢測儀紀錄清洗過程中紙張顏色的變化。(國立臺灣文學館典藏)


⭔ 施明正手繪鉛筆素描:鄭清文肖像(修復前後對比)
2021年初,臺文館前往紀念館檢視,這批畫作展示於會議室中。其中繪製「小說家鄭清文」的畫作,因吊掛的牆面緊鄰西曬窗,加上畫作直接接觸畫框的木製夾板,黃化變色最為嚴重,黃褐色底紙上的鉛筆線稿幾乎難以辨識人物輪廓。(國立臺灣文學館典藏)

⭔ 施明正手繪鉛筆素描:鍾肇政肖像
國立臺灣文學館典藏

⭔ 施明正手繪鉛筆素描:楊逵肖像
國立臺灣文學館典藏

⭔ 施明正手繪鉛筆素描:李魁賢肖像
國立臺灣文學館典藏

⭔ 施明正手繪鉛筆素描:何欣肖像
國立臺灣文學館典藏

⭔ 施明正手繪鉛筆素描:朱西甯肖像
國立臺灣文學館典藏

⭔ 施明正手繪鉛筆素描:李敏勇肖像
國立臺灣文學館典藏

⭔ 施明正手繪鉛筆素描:鄭炯明肖像
國立臺灣文學館典藏
⭔ 用生命撞擊藝術——施明正油畫修護記
國立臺灣文學館製作

